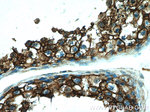
CD98 Antibody in Immunohistochemistry (Paraffin) (IHC (P))

Search
Proteintech
CD98 Polyclonal Antibody
{{$productOrderCtrl.translations['antibody.pdp.commerceCard.promotion.promotions']}}
{{$productOrderCtrl.translations['antibody.pdp.commerceCard.promotion.viewpromo']}}
{{$productOrderCtrl.translations['antibody.pdp.commerceCard.promotion.promocode']}}: {{promo.promoCode}} {{promo.promoTitle}} {{promo.promoDescription}}. {{$productOrderCtrl.translations['antibody.pdp.commerceCard.promotion.learnmore']}}
产品信息
15193-1-AP
种属反应
已发表种属
宿主/亚型
分类
类型
抗原
偶联物
形式
浓度
规格
纯化类型
保存液
内含物
保存条件
运输条件
产品详细信息
Immunogen sequence: KDDVAQTDL LQIDPNFGSK EDFDSLLQSA KKKSIRVILD LTPNYRGENS WFSTQVDTVA TKVKDALEFW LQAGVDGFQV RDIENLKDAS SFLAEWQNIT KGFSEDRLLI AGTNSSDLQQ ILSLLESNKD LLLTSSYLSD SGSTGEHTKS LVTQYLNATG NRWCSWSLSQ ARLLTSFLPA QLLRLYQLML FTLPGTPVFS YGDEIGLDAA ALPGQPMEAP VMLWDESSFP DIPGAVSANM TVKGQSEDPG SLLSLFRRLS DQRSKERSLL HGDFHAFSAG PGLFSYIRHW DQNERFLVVL NFGDVGLSAG LQASDLPASA SLPAKADLLL STQPGREEGS PLELERLKLE PHEGLLLRFP YAA (269-630 aa encoded by BC001061)
靶标信息
CD98 (4F2) is a type II transmembrane glycoprotein which serves as the heavy chain of the heterodimeric amino acid transporters (HATs). CD98, linked to various light chains by disulfide bond, is responsible for cell surface expression and basolateral localization of this transporter complex in polarized epithelial cells and also interacts with beta1 integrins and increases their affinity for ligand. Besides its roles in amino acid transport, CD98 is thus involved in cell fusion and activation. It is implicated in regulation of cellular differentiation, growth and apoptosis.
仅用于科研。不用于诊断过程。未经明确授权不得转售。
生物信息学
蛋白别名: 4F2 antigen heavy chain; 4F2 cell-surface antigen; 4F2 cell-surface antigen heavy chain; 4F2 heavy chain antigen; 4F2hc; Amino acid transporter heavy chain SLC3A2; antigen defined by monoclonal antibody 4F2, heavy chain; antigen identified by monoclonal antibodies 4F2; antigen identified by monoclonal antibodies 4F2, TRA1.10, TROP4, and T43; CD98; CD98 antigen; CD98 heavy chain; lymphocyte activation antigen; Lymphocyte activation antigen 4F2 large subunit; monoclonal antibody 44D7; solute carrier family 3 (activators of dibasic and neutral amino acid transport), member 2; solute carrier family 3 (amino acid transporter heavy chain), member 2; Solute carrier family 3 member 2; type II transmembrane protein; unnamed protein product
基因别名: 4F2; 4F2HC; 4T2HC; AI314110; CD98; CD98HC; Ly-10; Ly-m10; Ly10; MDU1; Mgp-2hc; NACAE; SLC3A2
UniProt ID: (Human) P08195, (Mouse) P10852
Entrez Gene ID: (Human) 6520, (Mouse) 17254